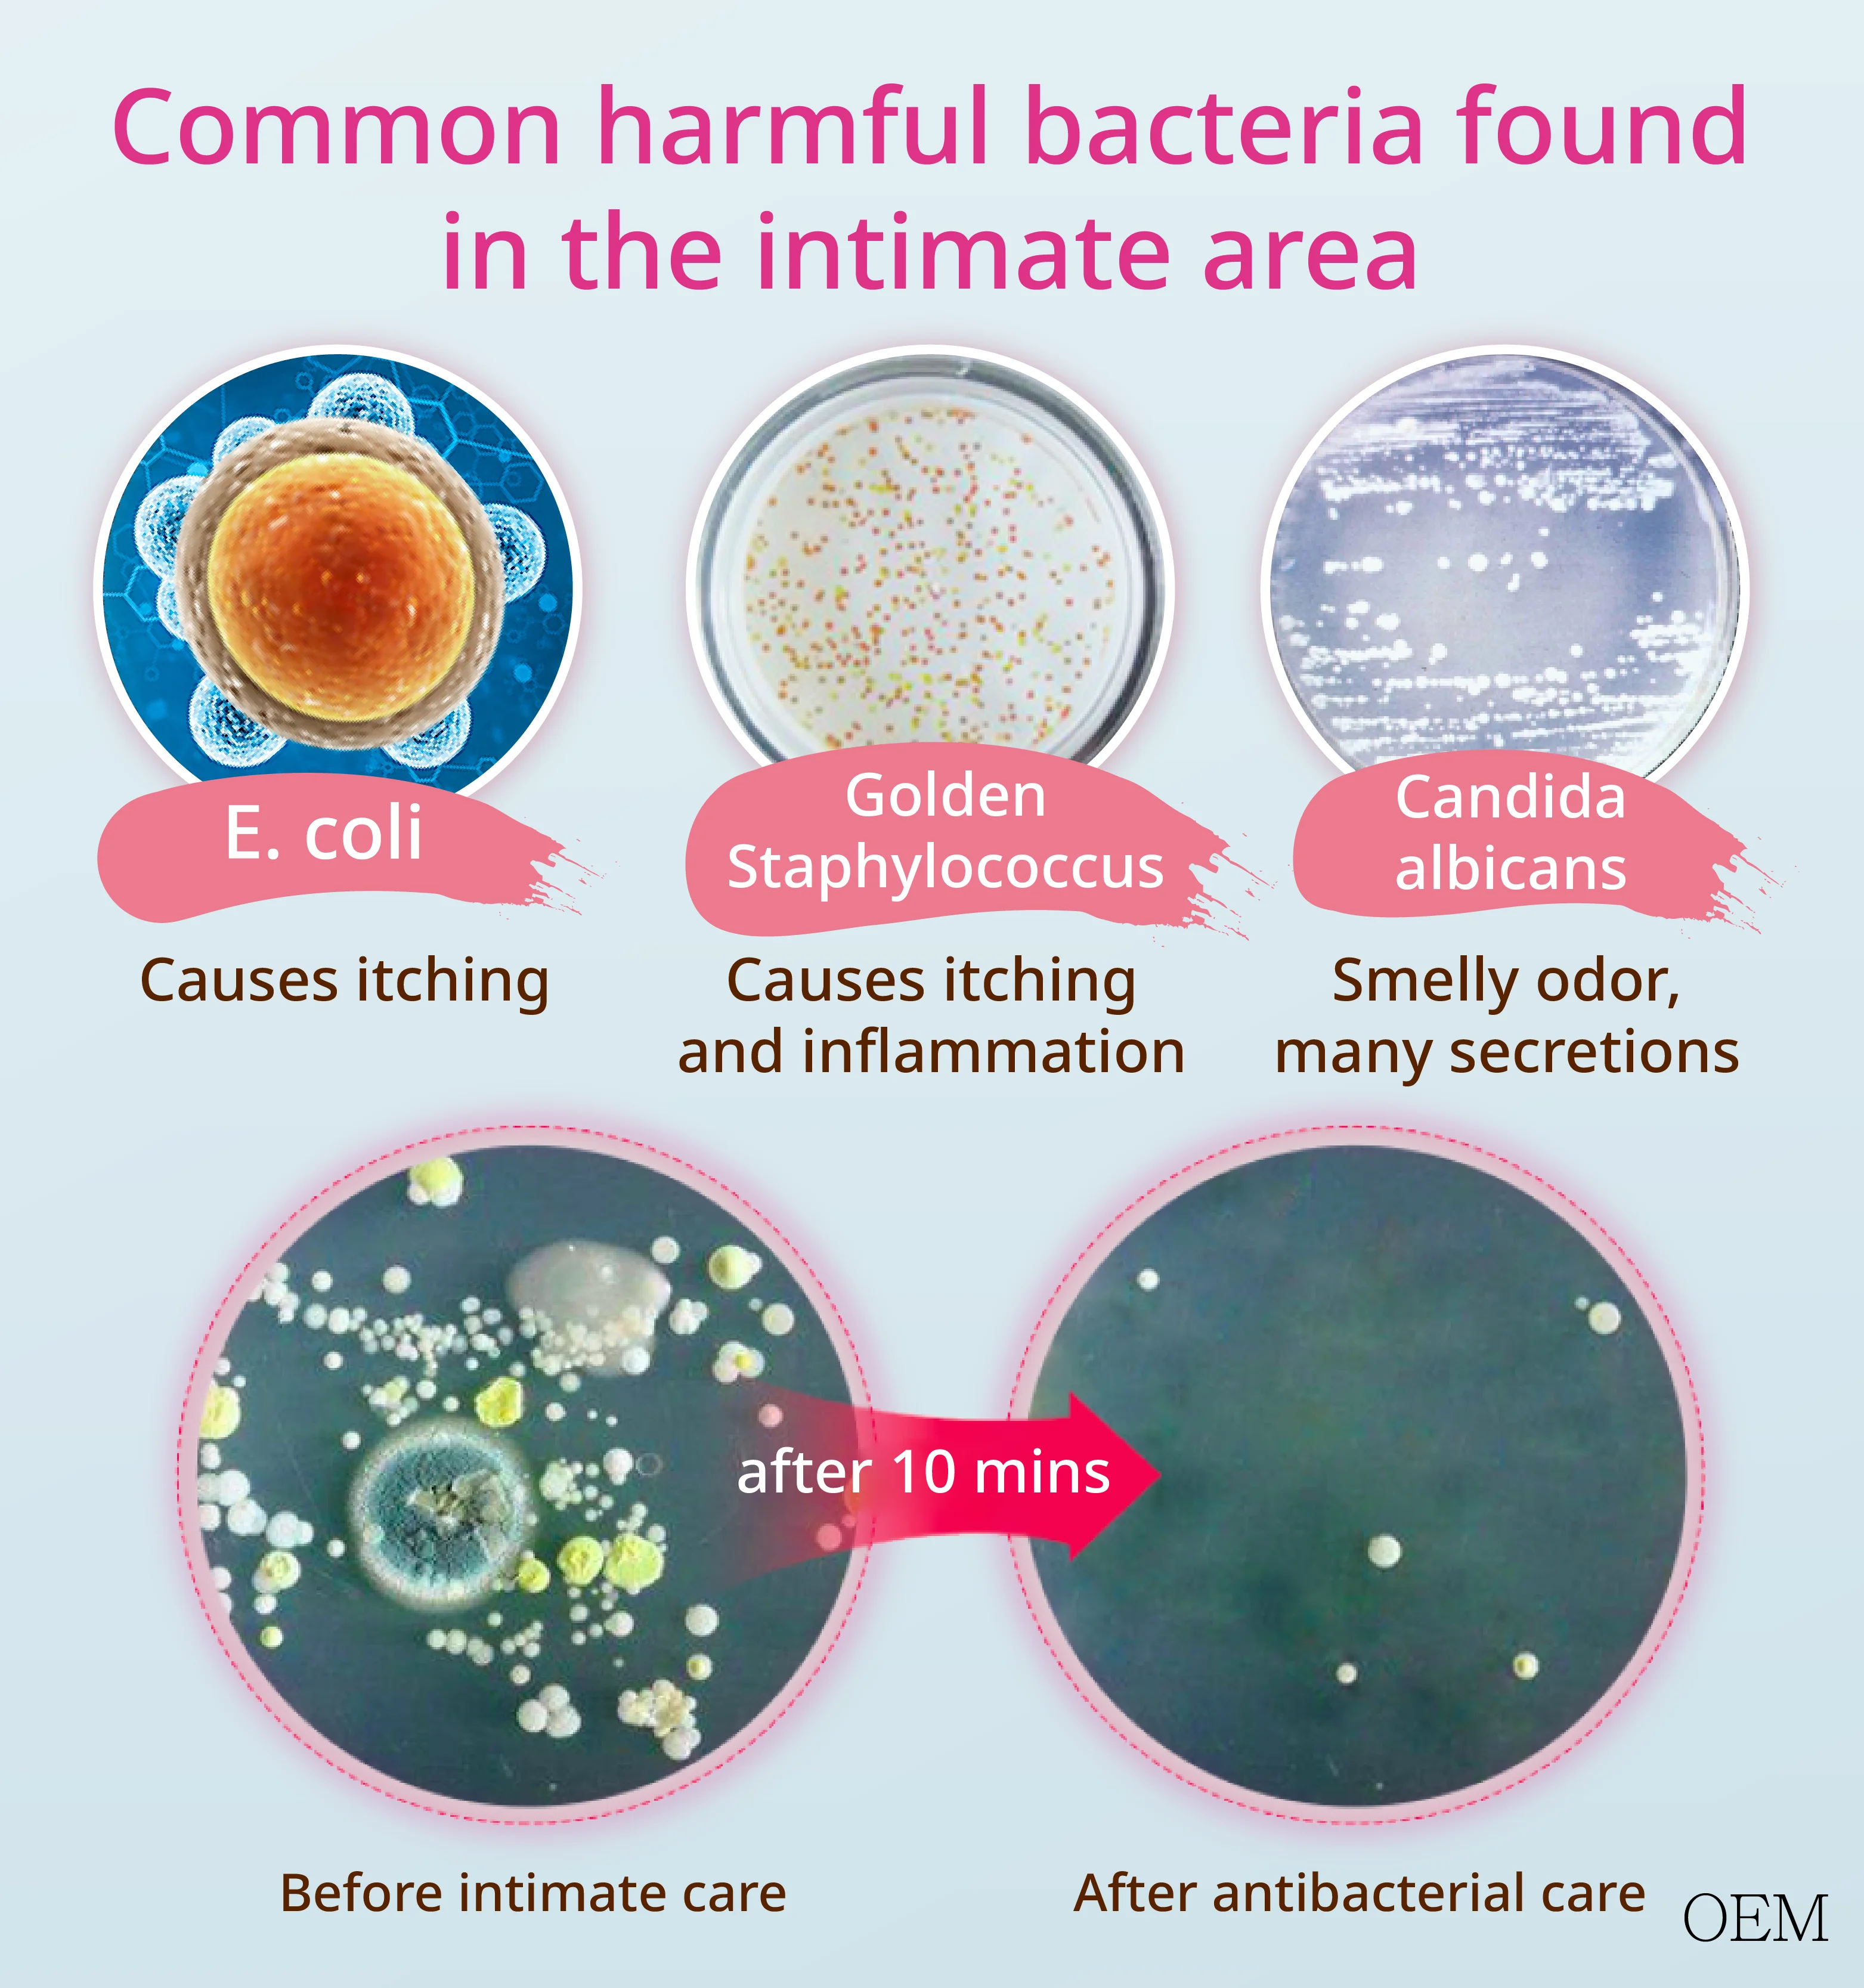

Женская стирка новейшие пробиотики женское Фирменное органическое Влагалищное
- Категории: Женственный моет >>>
- Поставщик: QUEEN,AESTHETICS,TECHNOLOGY,CO.,LTD.
Поделиться:
Описание и отзывы
Характеристики
Женственный стирки новые пробиотики женственная частная этикетка органическое вагинальные мыло для мытья

Детальные данные по продукции
| Название продукта | Женский yoni Вульва Вагина очищающий мусс |
| Название изделия | Вагинальный мыть |
| Другое название | Yoni стирка |
| Функция 1 | Отбеливает, антибактериально, ароматно и увлажняет |
| Функция 2 | Микромолекулярная плотная поролоновая занавеска, нанесите сначала, а затем постирайте |
| Характеристика | Делает интимную область кожи блестящей и упругой! |
| Тип | Ароматические и антибактериальные для поддержания pH влагалища |
| Материал | 100% из естественных трав |
| Объем | 150 мл |
| Упаковка | (Разработанно специально для заказчика)/поо (производство оригинального |
| Ключевые слова продукта | Вагинальный пробиотики, женственные частный ярлык вагинальный мыть, органические вагинальные мыло для мытья |
| Модель No. | RE0037 |
| Функция | Отбеливает, антибактериальный, ароматический, увлажняет интимную область кожи |
| Характеристика | Делает кожу интимной зоны блестящей и упругой. Улучшает запах, мягко состояние и балансирует уровень pH в интимной зоне. |
| Инструкции | Наносите его в течение 5-10 минут каждый день в качестве маски. Содержит антибактериальные ингредиенты для защиты вулвы. |
| Объем | 150 мл |
| Стандартная упаковка | 70 штук в картонной коробке |
| Объем коробки (см) | 50*39*21 |
| Вес коробки (кг) | 17 |
| Основные ингредиенты: | Лауройл натрия саркозинат, молочная кислота, лактококк фермент лизат, гидролизованный Manihot экстракт клубня эскуленты, o-Cymen-5-ol |
| Тип поставки | (Разработанно специально для заказчика)/поо (производство оригинального |
| Сертификация | SGS, ISO9001, GMP-ISO22716 |
| Срок годности | 36 месяцев |
| Оплата | 100% предоплата T/T, FOB |
| Цвет | Белый |
| Поставочной способностью | 10000 шт. в месяц |
| OEM/ODM время заказа | 14-25days |
| Отправочный пункт | Keelung, Taichung, Kaoshiung |
* 5 свежих преимуществ в 1 Очищающая стирка: мягко очищает и освежает, устраняет запах, вызывающий бактерии, pH сбалансированный, не содержит красителей и парабенов, клинически проверенный безопасный запах
* Протестированная формула дерматолога и гинеколога разработана специально для вагинальной области
PH сбалансирован для работы с естественной химией вашего тела
* Мягкая формула не раздражает вашу кожу, но она по-прежнему достаточно сильна, чтобы помочь очистить от запаха, вызывающего бактерии из области влагалища
Горячий продукт рекомендации
Aibaba СР
Dr. Держите СР
Https://www.dr-hold.com.tw/v2/official/SalePageCategory/312023?sortMode=Curator
Redance СР
Https://www.redance.com.tw/v2/official/SalePageCategory/132315?sortMode=Sales


























